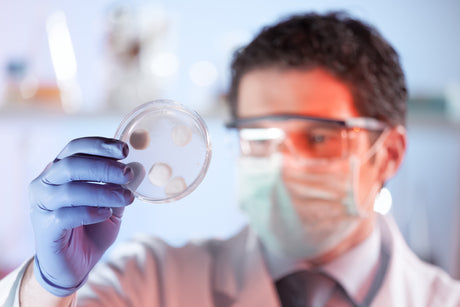

Collections
View allPromo grid
View AllSave up to
20%
Grain Neutral Spirits
Purchase now
Save up to
50%
Purchase Ethanol In Bulk
40-B Formula
Now
$1,800
Isopropyl Alcohol
Buy today
Save Big
Bulk
Tanker and Railcar Purchases
Buy in Bulk
Featured collection
Voir tout
Isopropyl Alcohol USP, Kosher Grade
Experience the pinnacle of purity with our Isopropyl Alcohol USP Kosher Grade. Meticulously crafted to meet the stringent standards of both the United States Pharmacopeia (USP) and the demanding requirements of Kosher certification, our Isopropyl Alcohol is a testament to quality and safety.
Our Isopropyl Alcohol is the trusted choice for pharmaceutical, food, cosmetic applications, and bulk alcohol needs. It's your assurance of a product that is not only compliant with the highest industry standards but also aligned with your ethical and dietary preferences.
Whether used in a medical setting, for sanitation, or in the preparation of your favorite Kosher dishes, our Isopropyl Alcohol USP Kosher Grade ensures both efficacy and peace of mind. Trust in the excellence of a product that consistently exceeds expectations and is ideal for bulk ethanol and bulk alcohol requirements. Elevate your standards with our Isopropyl Alcohol USP Kosher Grade today.
Applications
Ethanol comparison
Easily identify the most suitable ethanol product for specific needs, whether it's for medical purposes, industrial use, cleaning, or fuel, ensuring informed and cost-effective choices.